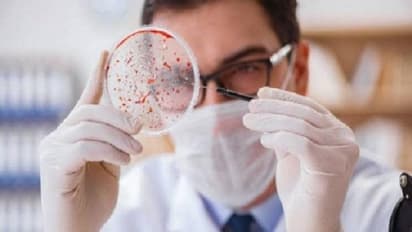
देश भर में बढ़ रहे हैं कैंसर के मामले, जानें क्या हैं कारण

हेल्थ डेस्क। कैंसर का खतरा लगातार बढ़ता ही जा रहा है। देश भर के अस्पतालों में कैंसर के मरीजों की संख्या में लगातार बढ़ोत्तरी हो रही है। कैंसर के मामलों में यह तेजी हाल के वर्षों में आई है। जीवनशैली और खान-पान की आदतों में आ रहे बदलाव को कैंसर की बीमारी बढ़ने का कारण माना जा रहा है। साल 2019 के नेशनल हेल्थ डाटा के अनुसार, 2017 और 2018 के बीच सामान्य कैंसर के मामलों में 324 प्रतिशत की वृद्धि हुई है। इसमें ओरल, सर्विकल और ब्रेस्ट कैंसर के मामले शामिल हैं। 2018 में 1.6 लाख लोग कैंसर के शिकार पाए गए, वहीं 2017 में कैंसर पीड़ितों की संख्या 39,635 थी।
एनसीडी क्लिनिक्स में आने वाले मरीजों की संख्या में भारी वृद्धि दर्ज की गई है। ये जिला अस्पतालों के वे क्लिनिक होते हैं जहां कैंसर, डायबिटीज, हायपरटेंशन, कार्डियोवैस्कुलर डिजीज और स्ट्रोक के मरीजों को रेफर किया जाता है। विशेषज्ञों का कहना है कि जीवनशैली में तेजी से बदलाव, खान-पान की बदलती आदतों, तनाव और शराब व तंबाकू के बढ़ते इस्तेमाल से कैंसर की बीमारी बढ़ रही है।
बताया गया कि कैंसर के सबसे ज्यादा मामले गुजरात में सामने आए। इसके बाद कर्नाटक, महाराष्ट्र, तेलंगाना और पश्चिम बंगाल में कैंसर के सबसे ज्यादा मामले देखे गए। यहां तक कि आंध्र प्रदेश और उत्तर प्रदेश जैसे राज्यों में जहां पहले कैंसर के कम मामले सामने आते थे, 2018 में इनमें तेज वृद्धि पाई गई।
एक्शन कैंसर हॉस्पिटल के सीनियर ओन्कोलॉजिस्ट डॉक्टर हरप्रीत सिंह का कहना है कि तंबाकू का बढ़ता इस्तेमाल ओरल कैंसर की प्रमुख वजह है। इसके अलावा, आरामदेह जीवनशैली और मोटापा बढ़ने से भी हर तरह के कैंसर के मामलों में बढ़ोत्तरी हो रही है।
स्वास्थ्य मंत्रालय कैंसर, डायबिटीज, कार्डियोवैस्कुलर डिजीज और स्ट्रोक के रोकथाम और इन पर नियंत्रण के लिए जागरूकता कार्यक्रम चलाने पर जोर दे रहा है। इसका उद्देश्य इन बीमारियों के जल्दी डायग्नोसिस के साथ लोगों की जीवनशैली में बदलाव लाना भी है।